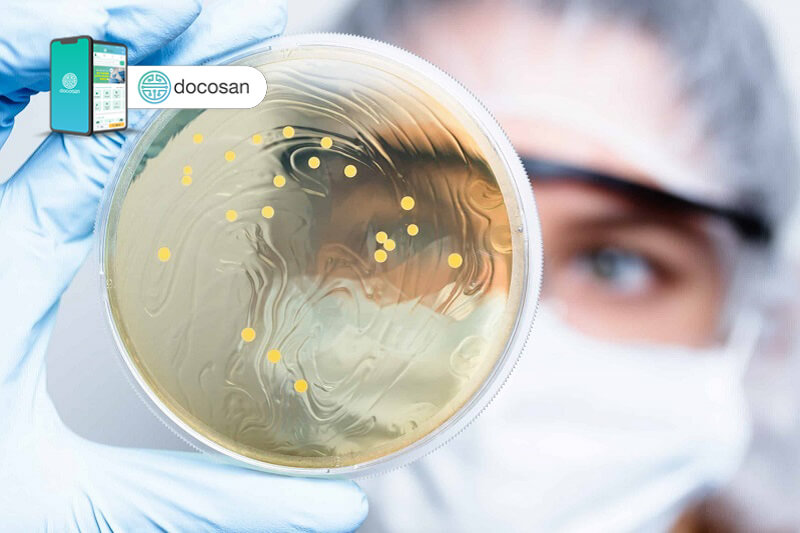

Thương hàn là một bệnh nhiễm trùng do vi khuẩn có thể dẫn đến sốt cao, tiêu chảy và nôn mửa. Bệnh được gây ra bởi vi khuẩn Salmonella typhi và có nguy cơ tử vong cao. Tuy nhiên, nếu bệnh thương hàn được phát hiện sớm, bệnh có thể được điều trị thành công bằng thuốc kháng sinh. Hãy cùng Doctor có sẵn tìm hiểu rõ hơn về bệnh lý này trong nội dung dưới đây ngay nhé!
Tóm tắt nội dung
Thương hàn là bệnh gì?
Thương hàn là một bệnh nhiễm trùng do vi khuẩn Salmonella typhimurium (S. typhi) gây ra. Vi khuẩn này sống trong ruột và máu của người. Nó lây lan bằng cách tiếp xúc trực tiếp với phân của người bị bệnh.
Không có loài động vật nào mang bệnh này, vì vậy sự lây truyền luôn là người sang người. Nếu không được điều trị, khoảng 1/5 trường hợp mắc bệnh thương hàn có thể gây tử vong. S. typhi xâm nhập qua miệng và sống trong ruột từ 1 đến 3 tuần. Sau đó, nó đi xuyên qua thành ruột và vào máu.
Từ máu, virus lan truyền vào các mô và cơ quan khác. Hệ thống miễn dịch của vật chủ có thể chống lại rất yếu vì S. typhi có thể sống trong tế bào của vật chủ, an toàn trước hệ miễn dịch.
Bệnh thương hàn được chẩn đoán bằng cách phát hiện sự hiện diện của S. typhi qua mẫu máu, phân, nước tiểu hoặc tủy xương.
Xem thêm:

Nguyên nhân gây bệnh cảm thương hàn
Sốt thương hàn do vi khuẩn nguy hiểm có tên là Salmonella typhi gây ra. Salmonella typhi có liên quan đến vi khuẩn gây ra bệnh nhiễm khuẩn salmonellosis, một bệnh nhiễm trùng đường ruột nghiêm trọng khác, nhưng chúng không giống nhau.
Lây truyền qua đường phân – miệng
Hầu hết ở các nước phát triển sẽ có nguy cơ nhiễm vi khuẩn thương hàn cao khi họ đang đi du lịch. Khi đã bị nhiễm bệnh, họ có thể lây cho người khác qua đường phân – miệng.
Điều này có nghĩa là vi khuẩn Salmonella typhi được truyền qua phân và đôi khi qua nước tiểu của người bị nhiễm bệnh. Nếu bạn ăn thức ăn đã được xử lý bởi người bị sốt thương hàn và không rửa cẩn thận sau khi đi vệ sinh, bạn có thể bị nhiễm bệnh.
Ở các nước đang phát triển, nơi có bệnh thương hàn, hầu hết mọi người bị nhiễm bệnh do uống nước bị ô nhiễm. Vi khuẩn cũng có thể lây lan qua thực phẩm bị ô nhiễm và qua tiếp xúc trực tiếp với người bị nhiễm bệnh.
Người đang nhiễm thương hàn
Ngay cả sau khi điều trị bằng thuốc kháng sinh, một số ít người khỏi bệnh sốt thương hàn vẫn tiếp tục chứa vi khuẩn. Những người này được gọi là người mang mầm bệnh mãn tính, không còn các dấu hiệu hoặc triệu chứng của bệnh. Tuy nhiên, chúng vẫn thải vi khuẩn theo phân và có khả năng lây nhiễm sang người khác.
Triệu chứng sốt thương hàn
Các triệu chứng thường bắt đầu từ 6 đến 30 ngày sau khi tiếp xúc với vi khuẩn. Hai triệu chứng chính của bệnh thương hàn là sốt và phát ban. Sốt thương hàn đặc biệt cao, tăng dần trong nhiều ngày, lên từ 39 đến 40 độ C.
Các triệu chứng khác có thể bao gồm:
- Ốm yếu
- Đau bụng
- Táo bón
- Đau đầu
Đôi khi, các triệu chứng có thể bao gồm lú lẫn, tiêu chảy và nôn mửa, nhưng điều này thường không nghiêm trọng.
Trong những trường hợp nghiêm trọng, không được điều trị, ruột có thể bị thủng. Điều này có thể dẫn đến viêm phúc mạc, nhiễm trùng mô lót bên trong bụng, đã được báo cáo là gây tử vong.
Một bệnh nhiễm trùng khác, sốt phó thương hàn, do Salmonella enterica gây ra. Nó có các triệu chứng tương tự như bệnh thương hàn, nhưng ít có khả năng gây tử vong hơn.
Ở mỗi giai đoạn bệnh thương hàn sẽ có diễn biến và các triệu chứng khác nhau, cụ thể như sau:
- Giai đoạn ủ bệnh
Thông thường, giai đoạn ủ bệnh kéo dài từ 7 – 15 ngày. Trong khoảng thời gian này, người bệnh không có triệu chứng.
- Giai đoạn khởi phát
Thường diễn biến trong 1 tuần với các triệu chứng như: Sốt tăng dần, thường có gai rét lúc đầu. Nhiệt độ có thể tăng cao lên đến 39 – 41 độ C đến ngày thứ 7 của bệnh. Bên cạnh triệu chứng sốt kéo cao kéo dài, người bệnh thương hàn còn thường hay gặp các triệu chứng như nhức đầu, mệt mỏi, ăn ngủ kém, ù tai.
- Giai đoạn toàn phát
Thường giai đoạn kéo dài trong khoảng 2 tuần với các triệu chứng như: Sốt, nhiễm độc thần kinh, đào ban, tiêu hóa, tiêm mạch.
Bệnh nhân thương hàn ở giai đoạn toàn phát thường sốt cao liên tục 39 – 40 độ C, với sốt nóng là chủ yếu. Bên cạnh đó, nhiễm độc thần kinh còn là triệu chứng nổi bật, biểu hiện bằng nhức đầu, ù tai, tay run, hay mất ngủ và gặp ác mộng. Điển hình của nhiễm độc thần kinh là trạng thái typhos. Khi đó, tuy người bệnh vẫn nhận biết các kích thích từ môi trường xung quanh nhưng vẫn nằm bất động, mắt nhìn đờ đẫn, vẻ mặt vô cảm. Trong một số trường hợp nặng hiếm gặp, bệnh nhân hôn mê, li bì.
Các nốt đào ban (hay hồng ban) dát nhỏ 2 – 3 mm có thể mọc ở bụng, ngực và mạn sườn. Số lượng ban ít, thường xuất hiện từ ngày 7 – 12 của bệnh. Bệnh nhân thương hàn còn gặp các vấn đề về tiêu hóa như đi ngoài phân lỏng sệt, màu vàng nâu, khoảng 5 – 6 lần mỗi ngày. Bụng của bệnh nhân thường chướng đau nhẹ lan tỏa vùng hố chậu phải. Ngoài ra, bệnh nhân thương hàn còn có thể gặp bệnh viêm phế quản, viêm phổi. Mạch chậm so với nhiệt độ của người bệnh thương hàn trong giai đoạn này được gọi là mạch và nhiệt độ phân ly.
- Giai đoạn lui bệnh
Giai đoạn này của bệnh thương hàn thường kéo dài trong khoảng 1 tuần. Nhiệt độ người bệnh dao động mạnh rồi giảm dần. Bệnh nhân phục hồi, đỡ mệt, ăn ngủ tốt hơn và hết các vấn đề về tiêu hóa.

Cảm hàn biến chứng là gì?
Chảy máu hoặc thủng ruột
Chảy máu hoặc thủng ruột là những biến chứng nghiêm trọng nhất của bệnh sốt thương hàn. Chúng thường phát triển vào tuần thứ ba của bệnh. Trong tình trạng này, ruột non hoặc ruột già phát triển một lỗ thủng. Các chất từ ruột rò rỉ vào dạ dày và có thể gây đau dạ dày nghiêm trọng, buồn nôn, nôn mửa và nhiễm trùng máu (nhiễm trùng huyết). Biến chứng đe dọa tính mạng này cần được chăm sóc y tế ngay lập tức.
Các biến chứng khác có thể xảy ra bao gồm:
- Viêm cơ tim
- Viêm màng trong tim và van (viêm nội tâm mạc)
- Nhiễm trùng các mạch máu lớn (chứng phình động mạch cơ)
- Viêm phổi
- Viêm tụy
- Nhiễm trùng thận hoặc bàng quang
- Nhiễm trùng và viêm màng và chất lỏng bao quanh não và tủy sống của bạn (viêm màng não)
- Các vấn đề tâm thần, chẳng hạn như mê sảng, ảo giác và rối loạn tâm thần hoang tưởng
Với phương pháp điều trị nhanh chóng, gần như tất cả người dân ở các quốc gia công nghiệp phát triển khỏi bệnh sốt thương hàn. Nếu không điều trị, một số người có thể không qua khỏi các biến chứng của bệnh.

Chẩn đoán bệnh thương hàn như thế nào?
Để chẩn đoán bệnh thương hàn chính xác, cần đưa bệnh nhân đến các bệnh viện hoặc các trung tâm y tế lớn được trang bị đầy đủ dụng cụ, máy móc và có các bác sĩ chuyên môn cao. Tại đó, các bác sĩ sẽ chẩn đoán bệnh thương hàn bằng cách dựa vào các triệu chứng lâm sàng như sốt hơn một tuần không rõ nguyên nhân, kèm rối loạn tiêu hóa, gan và lá lách to, nổi hồng ban. Ngoài ra, các bác sĩ còn chẩn đoán bệnh dựa vào phương pháp cận lâm sàng: Bạch cầu máu không tăng, phản ứng với huyết thanh Widal, PCR, RIA, ELISA,… Hay dựa vào kết quả cấy vi khuẩn (+).
Hướng điều trị bệnh thương hàn
Phương pháp điều trị hiệu quả duy nhất đối với bệnh thương hàn là dùng thuốc kháng sinh. Loại thuốc thường được sử dụng nhất là ciprofloxacin (cho người lớn không mang thai) và ceftriaxone.
Ngoài kháng sinh, điều quan trọng là phải bù nước bằng cách uống đủ nước. Trong trường hợp nghiêm trọng hơn, khi ruột đã bị thủng bệnh nhân có thể phải phẫu thuật.
Kháng thuốc kháng sinh thương hàn
Cũng như một số bệnh do vi khuẩn khác, hiện nay người ta lo ngại về việc S. typhi kháng thuốc kháng sinh ngày càng tăng. Điều này ảnh hưởng đến việc lựa chọn các loại thuốc có sẵn để điều trị thương hàn. Trong những năm gần đây, ví dụ, bệnh thương hàn đã trở nên kháng với trimethoprim-sulfamethoxazole và ampicillin.
Ciprofloxacin, một trong những loại thuốc chủ yếu trị thương hàn, cũng đang gặp khó khăn tương tự. Một số nghiên cứu đã phát hiện ra tỷ lệ kháng Salmonella typhimurium là khoảng 35%.

Phòng ngừa bệnh thương hàn
Nước uống sạch, cải thiện điều kiện vệ sinh và chăm sóc y tế đầy đủ có thể giúp ngăn ngừa và kiểm soát bệnh sốt thương hàn. Thật không may, ở nhiều quốc gia đang phát triển, những điều này có thể khó đạt được. Vì vậy, một số chuyên gia tin rằng vắc xin là cách tốt nhất để kiểm soát bệnh sốt thương hàn.
Nên tiêm vắc-xin nếu bạn sống hoặc đang đi du lịch đến những khu vực có nguy cơ bị sốt thương hàn cao.
Tiêm phòng Vắc-xin
Có hai loại vắc xin:
- Một mũi được tiêm trước khi đi du lịch ít nhất một tuần.
- Một loại được dùng bằng đường uống với bốn viên, với một viên được uống cách ngày.
Cần lưu ý: Không có vắc xin nào có hiệu quả 100%.
Vì vắc-xin không có khả năng bảo vệ hoàn toàn, hãy làm theo các hướng dẫn sau khi đi đến các khu vực có nguy cơ cao:
- Rửa tay: Thường xuyên rửa tay bằng nước nóng, xà phòng là cách tốt nhất để kiểm soát nhiễm trùng. Rửa sạch trước khi ăn hoặc chế biến thức ăn và sau khi đi vệ sinh. Mang theo chất khử trùng tay có cồn cho những lúc không có nước.
- Tránh uống nước chưa qua xử lý: Nước uống bị ô nhiễm là một vấn đề đặc biệt ở những khu vực có nguy cơ mắc bệnh thương hàn. Vì lý do đó, chỉ uống nước đóng chai hoặc đồ uống có ga, rượu, bia đóng hộp hoặc đóng chai. Nước đóng chai có ga an toàn hơn nước đóng chai không ga.
- Yêu cầu đồ uống không có đá: Sử dụng nước đóng chai để đánh răng và cố gắng không nuốt nước khi tắm.
- Không sử dụng trái cây và rau sống: Vì sản phẩm sống có thể đã được rửa trong nước bị ô nhiễm, nên tránh các loại trái cây và rau mà bạn không thể gọt vỏ. Để an toàn tuyệt đối, bạn có thể tránh hoàn toàn thực phẩm sống.
- Chọn thức ăn đã nấu chín, còn nóng: Tránh thực phẩm được bảo quản hoặc phục vụ ở nhiệt độ phòng. Sử dụng thức ăn nóng là tốt nhất. Và mặc dù không có gì đảm bảo rằng các bữa ăn được phục vụ tại các nhà hàng tốt nhất là an toàn, nhưng tốt nhất bạn nên tránh thức ăn từ những người bán hàng rong – nó có nhiều khả năng bị nhiễm bệnh hơn.

Ngăn ngừa lây nhiễm cho người khác
Nếu bạn đang hồi phục sau sốt thương hàn, các biện pháp này có thể giúp giữ an toàn cho những người khác:
- Uống thuốc kháng sinh: Làm theo hướng dẫn của bác sĩ khi dùng thuốc kháng sinh và nhớ uống hết toàn bộ đơn thuốc
- Rửa tay thường xuyên: Đây là điều quan trọng nhất bạn có thể làm để tránh lây nhiễm cho người khác. Dùng nước nóng, xà phòng và cọ rửa kỹ trong ít nhất 30 giây, đặc biệt là trước khi ăn và sau khi đi vệ sinh.
- Tránh tiếp xúc với thức ăn của người khác: Tránh chế biến thức ăn cho người khác cho đến khi bác sĩ cho biết bạn không còn lây nhiễm nữa. Nếu bạn làm việc trong ngành dịch vụ thực phẩm hoặc cơ sở chăm sóc sức khỏe, bạn sẽ không được phép trở lại làm việc cho đến khi các xét nghiệm cho thấy bạn không còn phát tán vi khuẩn thương hàn.











